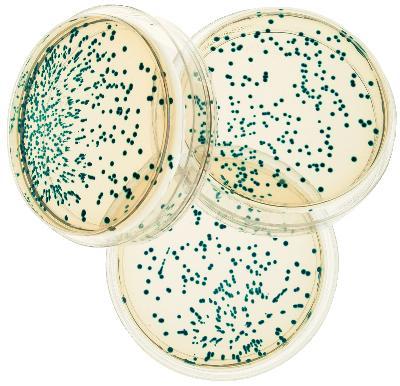

Transformation/E. Coli/Pgal, Blue Colony, Pack Of 1
$ 142.90
|
|
Details:
Transformation/E. Coli/pGal, Blue Colony
Additional Information
| SKU | 23296900 |
|---|---|
| UOM | Pack of 1 |
| UNSPSC | 41106203 |
| Manufacturer Part Number | 221 |
| Product Dimensions | 13.4X10.2X4.6 Inches |
| Product Weight | 2.7 |
